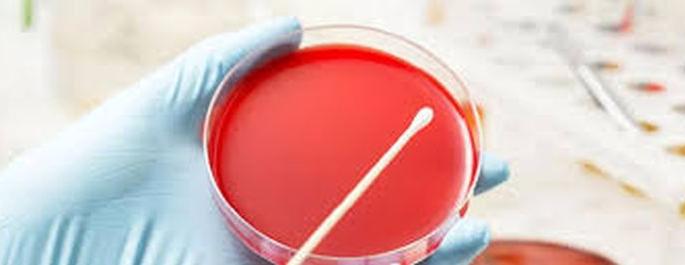

कवठळ येथील तिघांसह २६ जणांच्या थ्रोट स्वॅब नमुने अहवालाची प्रतिक्षा
By लोकमत न्यूज नेटवर्क | Updated: June 2, 2020 10:50 IST2020-06-02T10:49:59+5:302020-06-02T10:50:46+5:30
या नमुन्याचा अहवाल नेमका काय येतो, याकडे आरोग्य विभागासह जिल्हावासियांचे लक्ष लागून आहे.
कवठळ येथील तिघांसह २६ जणांच्या थ्रोट स्वॅब नमुने अहवालाची प्रतिक्षा
लोकमत न्यूज नेटवर्क
वाशिम : कवठळ ता. मंगरूळपीर येथील मृत कोरोनाबाधित रुग्णाच्या कुटुुंबातील तिघांसह जिल्हयतून २६ जणांचे थ्रोट स्वॅब नमुने तपासणीसाठी १ जून रोजी अकोला येथे पाठविण्यात आले. या नमुन्याचा अहवाल नेमका काय येतो, याकडे आरोग्य विभागासह जिल्हावासियांचे लक्ष लागून आहे.
इतर जिल्ह्याच्या तुलनेत वाशिम जिल्ह्यात कोरोनाबाधित रुग्णांची संख्या कमी ठेवण्यात जिल्हा प्रशासनासह आरोग्य व पोलीस यंत्रणेने सुरूवातीपासूनच यश मिळविले. अलिकडच्या काळात परराज्यातून येणाऱ्या मजूर, कामगारांमुळे जिल्ह्यातील संदिग्ध रुग्णांची संख्या वाढत होती. दरम्यान कवठळ येथील एक जण कोरोनाबाधित असल्याचे १० मे रोजी वर्धा जिल्ह्यात निष्पन्न झाले होते. या व्यक्तीच्या संपर्कातील सर्वांचे अहवाल निगेटिव्ह आले होते. दरम्यान, या रूग्णाची प्रकृती २० मे नंतर बिघडली. त्याला जीवनदायी प्रणालीवर (व्हेंटिलेटर) ठेवण्यात आले; परंतु प्रकृतीत कोणतीही सुधारणा झाली नाही. अखेर २९ मे रोजी पहाटे २ वाजता त्यांचा मृत्यू झाला. त्यांच्यावर वर्धा येथील स्मशानभूमीतच अंत्यसंस्कार करण्यात आले. अंत्यसंस्काराला कुटुंबातील तीन जण गेले होते. कोणताही संभाव्य धोका नको म्हणून तिघांचे थ्रोट स्वॅब नमुने तपासणीसाठी १ जून रोजी अकोला पाठविण्यात आले, अशी माहिती जिल्हा शल्य चिकित्सक डॉ. अंबादास सोनटक्के यांनी दिली.
याशिवाय मानोरा, रिसोड, वाशिम, मालेगाव, कारंजा या तालुकास्तरावरून अन्य २३ जणांचे थ्रोट स्वॅब नमुने तपासणीसाठी पाठविण्यात आले आहे. सर्दी, ताप, खोकला, घसा दुखणे आदी लक्षणांचा यामध्ये समावेश आहे.
आतापर्यंत २२० जणांचे थ्रोट स्वॅब नमुने तपासणीसाठी पाठविण्यात आले होते. यापैकी १८५ जणांचे अहवाल निगेटिव्ह आले तर आठ जणांचे अहवाल पॉझिटिव्ह आले होते. यामध्ये दोन जणांचा मृत्यू झाला तर सहा जणांनी कोरोनावर मात केल्याने त्यांना रुग्णालयातून सुटी देण्यात आली आहे. उर्वरीत २७ जणांच्या नमुन्याचा अहवाल प्रलंबित आहे.